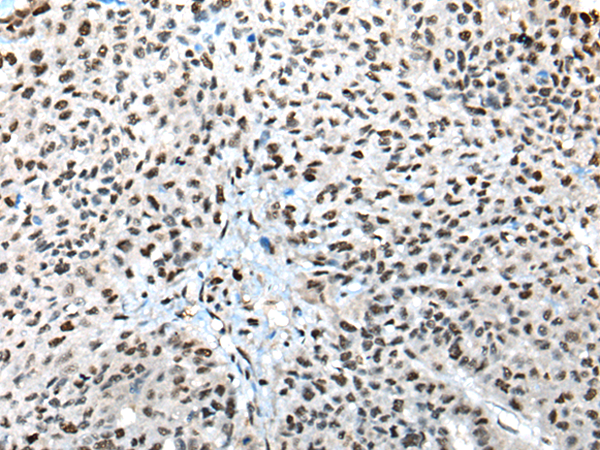
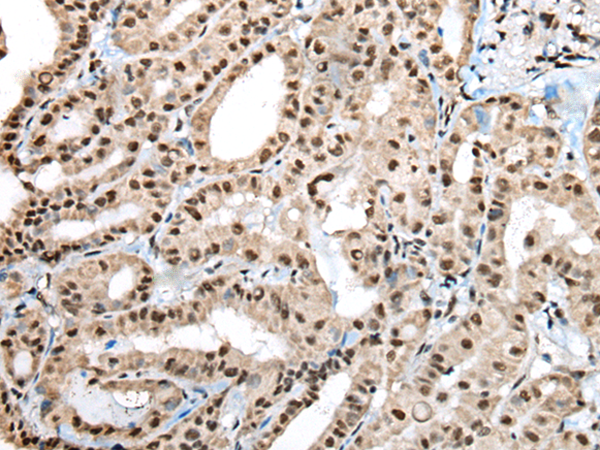
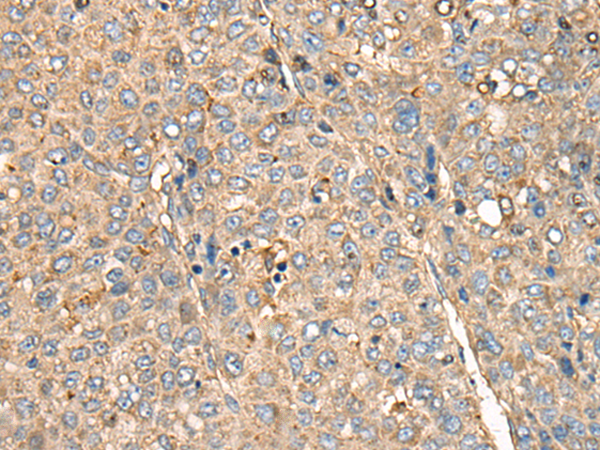

-
分类: 科研抗体货号: P09378别名: AT; ATK; BPK; XLA; IMD1; AGMX1; IGHD3; PSCTK1应用: IHC反应种属: Human, Mouse
-
分类: 科研抗体货号: P09387别名: C14orf80应用: WB,IHC反应种属: Human
-
分类: 科研抗体货号: P09392别名: C17orf66应用: IHC反应种属: Human
-
分类: 科研抗体货号: P09377别名:应用: WB,IHC反应种属: Human, Mouse
-
分类: 科研抗体货号: P09386别名:应用: IHC反应种属: Human, Mouse
-
分类: 科研抗体货号: P09391别名: C17orf61应用: IHC反应种属: Human, Mouse
-
分类: 科研抗体货号: P09401别名: C1orf114应用: WB,IHC反应种属: Human, Mouse
-
分类: 科研抗体货号: P09385别名: C14orf130应用: WB,IHC反应种属: Human, Mouse
-
分类: 科研抗体货号: P09390别名: gs129; C16orf73应用: IHC反应种属: Human
-
分类: 科研抗体货号: P09400别名: C1orf106应用: IHC反应种属: Human, Mouse

鄂公网安备42018502007531号
鄂公网安备42018502007531号

